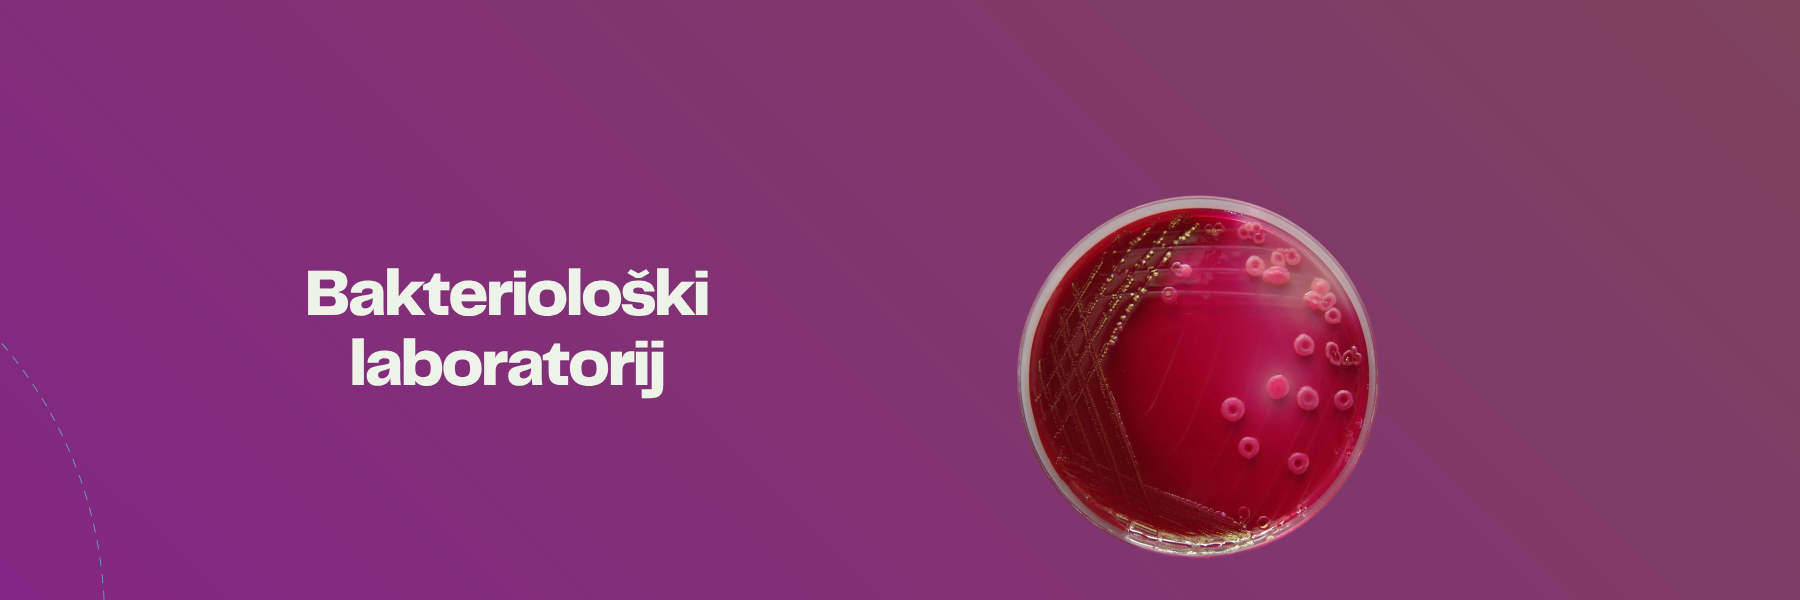

Klinički značajna bakterija Acinetobacter baumannii izvan bolničkog okruženja u Hrvatskoj
Iscrpljivanje bakterije Escherichie coli na selektivnoj podlozi
Escherichia coli i utjecaj antibiotika
Precjeplivanje bakterija u bakteriološkom laboratoriju
Izolacija anaerobnih bakterija iz površinskih voda
Uklanjanje patogene bakterije Acinetobacter baummani pomoću zeolita

 Pristupačnost
Pristupačnost